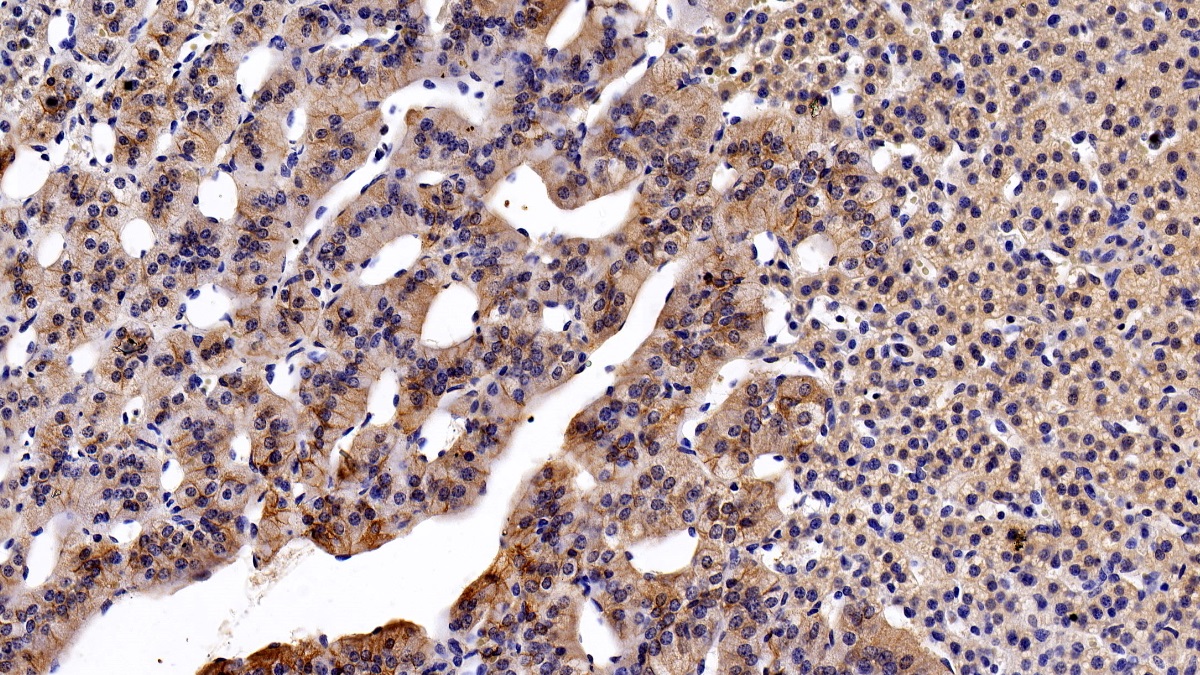

| Pack Size | 100ul, 1ml, 200ul, 20ul |
|---|---|
| Applications | WB; IHC; ICC; IP. |
| Host Species | Mouse |
| Ig Isotype | IgG2b Kappa |
| Antibody Type | Monoclonal Antibody |
| Organism Species | Homo sapiens (Human) |
| Concentration | 1 mg/ml |
| Product Synonyms | Activated Leukocyte Cell Adhesion Molecule (ALCAM) |
| Alternative Names | CD166; MEMD; Activated Leucocyte Cell Adhesion Molecule |
| Immunogen (Antigen) | Activated Leukocyte Cell Adhesion Molecule |
| Buffer Formulation | 0.01M PBS, 50% glycerol., containing 0.05% Proclin-300, pH7.4 |
| Reactivity | Po; |
| Uniprot ID | Q13740 |
| Gene ID | 214 |
| Potency (Clone Number) | 5-2# |
| Purification | Antigen-specific affinity chromatography followed by Protein A affinity chromatography |
| Usage | For Research Use Only. Not for diagnostics or human use. |
| Shelf Life | 12 months at time of shipping |
| Shipping | Shipped in Dry Ice at -20 Degree Celsius |
| Storage | Store at -20 Degree Celsius. It is recommended to aliquot and store to avoid repeated freeze-thaw as it affects the stability of the antibody. |
| Research Areas | Cell Biology, Developmental Biology, Immunology |
| KD/KO Validated | KD Validated |
| Disclaimer | The data indicated herein are as indicated and validated in our laboratory. These reagents are for research use only and not for in-vitro diagnostics or human use. |
Activated Leukocyte Cell Adhesion Molecule (ALCAM) Human Monoclonal Antibody
Price range: $20.00 through $200.00

![Bid Rabbit Monoclonal Antibody [KD Validated]](https://www.kinesisdx.com/wp-content/uploads/2025/05/A23234_ARC59702-01_WB_01-370x444.jpg)
![ERK1 Rabbit Monoclonal Antibody [KD Validated]](https://www.kinesisdx.com/wp-content/uploads/2025/05/A19561_ARC2591_WB_01-370x444.jpg)
![Casein Kinase 2 alpha (CSNK2A1) Rabbit Monoclonal Antibody [KD Validated]](https://www.kinesisdx.com/wp-content/uploads/2025/05/A19683_ARC0163_WB_01-370x444.jpg)
![Annexin A1/ANXA1 Rabbit Monoclonal Antibody [KD Validated]](https://www.kinesisdx.com/wp-content/uploads/2025/05/A25918_ARC66904-01_WB_01-370x444.jpg)

![BUB1 Rabbit Monoclonal Antibody [KD Validated]](https://www.kinesisdx.com/wp-content/uploads/2025/05/A23198_ARC59688-01_KO-WB_01-370x444.jpg)
Reviews
There are no reviews yet.